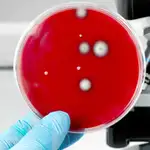
La lucha contra las infecciones por superbacterias va con retraso

Organismos
Científicos descubren la bacteria más grande del mundo, que puede llegar a tener el tamaño de una mosca
Bautizada como “Thiomargarita magnifica” por un equipo internacional de investigadores, la bacteria eclipsa a otras llamadas “gigantes” al superar 50 veces su tamaño

Hasta que Antoni van Leeuwenhoek descubrió las bacterias por primera vez en 1676, ni siquiera teníamos un nombre para estas diminutas formas de vida. De la misma forma ocurría con los virus, que son más pequeños que las bacterias y requieren microscopios aún más potentes para observarlos, ya que no se descubrieron hasta 1892, cuandoDmitry Ivanovsky aisló el virus del mosaico del tabaco. Por tantro, imagine la sorpresa de todos cuando los científicos descubrieron recientemente una bacteria tan grande que es visible a simple vista. Esta bacteria gigante con forma de hilo, originaria de los manglares del Caribe, puede crecer hasta 2 centímetros de largo, aproximadamente el tamaño de una mosca. Es unas 5.000 veces más grande que la mayoría de microbios, lo que amplia los límites de lo que conocíamos, biológicamente hablando, de un organismo unicelular. Bautizada como “Thiomargarita magnifica” por un equipo internacional de investigadores, que incluía científicos del Laboratorio Nacional Lawrence Berkeley en los Estados Unidos, la bacteria eclipsa a otras llamadas “gigantes” al superar 50 vecessu tamaño.
La bacteria se dio a conocer en un borrador publicado la semana pasada y ha asombrado a algunos de los investigadores que han revisado sus características. “Cuando se trata de bacterias, nunca digo nunca, pero esta seguro está superando lo que pensábamos que era el límite superior (de tamaño) por 10 veces”, explica Verena Carvalho, microbióloga de la Universidad de Massachusetts, Amherst. “Con demasiada frecuencia, se piensa que las bacterias son formas de vida pequeñas, simples y ‘no evolucionadas’, las llamadas ‘bolsas de proteínas’. Pero esta bacteria muestra que aún estamos lejos de la verdad”, confesó, por su parte, Chris Greening, microbiólogo de la Universidad de Monash, Clayton, que, al igual que Carvalho, no participó en el estudio.
Una disposición genética atípica
El secreto del gran tamaño de la bacteria “Thiomargarita magnifica”puede residir en la disposición de su material genético, que es totalmente atípico. Las bacterias y otros organismos unicelulares, llamados arqueas,se clasifican como procariotas, mientras que los organismos pluricelulares, como las plantas o los seres humanos, se clasifican como eucariotas. Una de las diferencias base entre estos dos grupos es que los organismos procariotas tienen ADN que flota libremente, mientras que los eucariotas empaquetan su código genético en un núcleo. Sin embargo, esta nueva bacteria está borrando las marcadas líneas entre eucariotas y procariotas, ya que su enorme genoma no flota libremente dentro de su célula como en otras bacterias, sino que está encerrado en una membrana.
Cuando los investigadores secuenciaron el genoma, quedaron asombrados por su tamaño: 11 millones de bases que se alinean para formar 11.000 genes. A modo de comparación, una bacteria común y corriente solo tiene alrededor de 4 millones de bases y alrededor de 3.900 genes. “Es importante destacar que mostramos que los filamentos de Thiomargarita de un centímetro de largo representan células individuales con material genético y ribosomas compartimentados en un nuevo tipo de orgánulo unido a la membrana. La secuenciación y el análisis de los genomas de cinco células individuales revelaron información sobre distintos mecanismos de división celular y elongación celular”, escribieron los investigadores en un artículo publicado en “bioRxiv”.
Estos hallazgos extraordinarios sugieren que las dos ramas en las que se divide la vida no son tan diferentes después de todo. Y que “T. magnifica” podría ser el eslabón perdido que explica cómo evolucionó la vida compleja a partir de los organismos unicelulares más primitivos hace más de mil millones de años. “T. magnifica se suma a la lista de bacterias que han evolucionado a un mayor nivel de complejidad. Es la primera y única bacteria conocida hasta la fecha que segregan inequívocamente su material genético en orgánulos unidos a la membrana a la manera de los eucariotas y, por lo tanto, desafía nuestro concepto de célula bacteriana”, confesaron los investigadores.
✕
Accede a tu cuenta para comentar